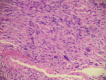

Leiomyosarcoma of the urinary bladder: A review and a report of two further cases
- PMID: 26558075
- PMCID: PMC4443010
- DOI: 10.1016/j.aju.2013.03.004
Leiomyosarcoma of the urinary bladder: A review and a report of two further cases
Abstract
Objectives: To review the published cases of leiomyosarcoma of the urinary bladder and to report two further cases.
Methods: The databases Pubmed and Hinari were searched using the keywords 'bladder', 'leiomyosarcoma' and 'smooth muscle neoplasm'. The 14 articles identified were reviewed, and we present a further two cases.
Results: Of more than 100 cases reported, 77 were reviewed. There is a lack of consensus about the standard treatment, and little is known about the natural history and prognosis of the tumour, due to its very low incidence. These tumours occur in older adults of either sex and are characterised by an aggressive behaviour. There is usually an unfavourable outcome, with the lungs being the most common site of metastasis. The two further cases we report had a different presentation and outcome.
Conclusions: Because of the limited experience with this rare tumour, there are insufficient data to suggest the optimum management strategy and prognosis.
Keywords: FNCLCC, Fédération Nationale des Centres de Lutte Contre le Cancer; HPF, high-power fields; Leiomyosarcoma; MSKCC, Memorial Sloan Kettering Cancer Center; Management; Outcome; Urinary bladder.
Figures

References
-
- Lee T.K., Miyamoto H., Osunkoya A.O., Guo C.C., Weiss S.W., Epstein J.I. Smooth muscle neoplasms of the urinary bladder. A clinicopathologic of study 51 cases. Am J Surg Pathol. 2010;34:502–509. - PubMed
-
- Tanguay C., Harvey I., Houde M., Srigley J.R., Têtu B. Leiomyosarcoma of urinary bladder following cyclophosphamide therapy. A report of two cases. Mod Pathol. 2003;5:512–514. - PubMed
Publication types
LinkOut - more resources
Full Text Sources
Other Literature Sources
